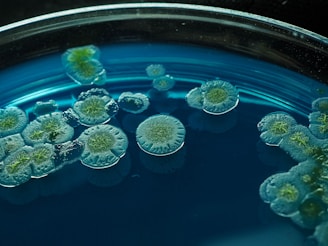
a group of green flowers floating in a blue bowl

bienvenidos al portal de ingeniería en biotecnología modalidad virtual
¿Qué es el Trabajo de Campo?
El Trabajo de Campo (TC) es un componente académico del plan de estudios de la carrera de Ingeniería en Biotecnología que permite aplicar los conocimientos teóricos en contextos reales relacionados con la biotecnología.
A través de estas actividades, los estudiantes desarrollan competencias en:
experimentación científica
análisis de datos biológicos
investigación científica
aplicación de biotecnología en contextos reales
El Trabajo de Campo forma parte de los créditos académicos del programa educativo.


Requisitos
De acuerdo con el plan de estudios:
Cada semestre contempla 80 horas de Trabajo de Campo
Durante la carrera se deben acumular 480 horas en total
Las horas pueden realizarse mediante diferentes actividades académicas, científicas, tecnológicas o profesionales relacionadas con la biotecnología.


Modalidades del Trabajo de Campo
Para facilitar su cumplimiento, las actividades pueden realizarse en distintas modalidades:
Modalidad experimental
Actividades relacionadas con experimentación y laboratorio.
Ejemplos:
prácticas de laboratorio, cultivos microbianos, experimentos biológicos
Modalidad aplicada
Actividades en empresas, campo o proyectos productivos.
Ejemplos:
estancias en empresas, proyectos agrícolas o ambientales, diagnósticos productivos
Modalidad digital o computacional
Actividades realizadas mediante herramientas informáticas.
Ejemplos:
análisis bioinformático, análisis estadístico de datos biológicos, programación científica
Modalidad académica
Actividades de producción científica.
Ejemplos:
revisión de literatura científica, redacción de artículos científicos, participación en congresos




Catálogo de actividades
El programa cuenta con un catálogo de más de 100 actividades mediante las cuales se puede acreditar el Trabajo de Campo.
Cada actividad tiene asignada una equivalencia de horas, dependiendo de su complejidad.


Liberación parcial o total
En algunos casos, actividades académicas de alto impacto pueden acreditar parte o la totalidad de las 480 horas, tales como:
publicación de artículos científicos
participación en proyectos de investigación
desarrollo de software científico
desarrollo de proyectos experimentales relevantes
Estas actividades deberán ser evaluadas y autorizadas por el departamento.

Iniciar Registro
Antes de llenar el formulario tenga a la mano:
Nombre de la institución
Nombre del responsable
Cargo del responsable
Ciudad y estado de la institución
Solicitar Carta de Presentación
Formato de Carta de Aceptación de Trabajo de Campo
Descarga este formato para que la institución, empresa, laboratorio o responsable donde realizarás tus actividades de Trabajo de Campo confirme tu aceptación para desarrollar las actividades correspondientes.
El documento deberá ser llenado, firmado por el responsable y posteriormente subirlo
Registro de Trabajo de Campo
En este apartado el estudiante deberá registrar la actividad que realizará como parte del Trabajo de Campo del Programa Educativo de Ingeniería en Biotecnología.
Primero deberá llenar el formulario de registro, con la información de la institución, proyecto o actividad donde desarrollará sus actividades, así como los datos del responsable o supervisor.
Una vez enviado el formulario, se generará el Formato de Inscripción al Trabajo de Campo, el cual le llegara a su Email y deberá ser:
Revisado y firmado por el estudiante.
Firmado por el responsable o supervisor de la actividad.
Posteriormente subido nuevamente al sistema para su validación y firma por parte del Coordinador del Programa Educativo.
Este documento formará parte del expediente digital del estudiante y permitirá dar seguimiento académico a las actividades realizadas durante el Trabajo de Campo.
Reporte de Actividades de Trabajo de Campo
En este apartado el estudiante deberá registrar el Reporte de Actividades de Trabajo de Campo una vez concluida la actividad realizada.
Primero deberá llenar el formulario correspondiente, a partir del cual se generará el Formato de Reporte de Actividades de Trabajo de Campo. Este documento deberá ser descargado, impreso y firmado por el estudiante y por el responsable o supervisor de la actividad.
Posteriormente, el formato firmado deberá subirse nuevamente al sistema junto con un archivo de evidencias, para su revisión y validación por parte del Coordinador del Programa Educativo, quien acreditará las horas correspondientes conforme al catálogo de actividades del Trabajo de Campo.
El reporte validado será integrado al expediente digital del estudiante como parte del proceso de cumplimiento del Trabajo de Campo.
Nota aclaratoria sobre la entrega de evidencias del Trabajo de Campo
Con el propósito de facilitar la organización y revisión de las actividades realizadas durante el Trabajo de Campo, el Programa Educativo de Ingeniería en Biotecnología ha establecido un formato de entrega de evidencias que permite documentar de manera ordenada las actividades, resultados y evidencias fotográficas correspondientes.
Sin embargo, debido a la naturaleza diversa de las actividades contempladas en el catálogo de Trabajo de Campo, en algunos casos las evidencias pueden consistir en productos académicos o documentos formales generados durante la actividad, tales como:
artículos científicos o manuscritos,
reportes técnicos o informes de investigación,
constancias de participación en proyectos o eventos académicos,
documentos de resultados experimentales o análisis realizados,
presentaciones académicas u otros productos derivados de la actividad.
En estos casos, el estudiante podrá subir directamente dichos documentos como evidencia, sin necesidad de integrarlos al formato de evidencias, siempre que el archivo presentado permita identificar claramente la actividad realizada y la participación del estudiante.
Cuando las evidencias incluyan fotografías, registros de actividades o diversos documentos, se recomienda utilizar el formato de entrega de evidencias proporcionado, integrando toda la información en un solo archivo PDF.
La entrega de evidencias será revisada por el Coordinador del Programa Educativo, quien determinará la validez de la documentación presentada y la acreditación de las horas correspondientes conforme al catálogo de actividades del Trabajo de Campo.
Solicitud de Constancia de Liberación de Trabajo de Campo
En este apartado los estudiantes podrán solicitar la Constancia de Cumplimiento del Trabajo de Campo correspondiente al Programa Educativo de Ingeniería en Biotecnología.
Antes de realizar esta solicitud, el estudiante deberá verificar que ha cumplido con el total de 480 horas de Trabajo de Campo, así como haber entregado previamente todos los registros, reportes de actividades y evidencias correspondientes a las actividades realizadas.
La información será revisada por la Coordinación del Programa Educativo, quien verificará el expediente digital del estudiante. En caso de confirmarse el cumplimiento de las 480 horas establecidas en el plan de estudios, se procederá a la emisión de la constancia oficial de liberación de Trabajo de Campo.
Se recomienda realizar esta solicitud únicamente cuando el estudiante tenga la certeza de haber completado la totalidad de las horas requeridas, ya que la constancia solo podrá emitirse una vez validado el cumplimiento del requisito.

© 2026 Universidad Autónoma Indígena de México (UAIM). Portal informativo del Programa Educativo de Ingeniería en Biotecnología – Modalidad Virtual.